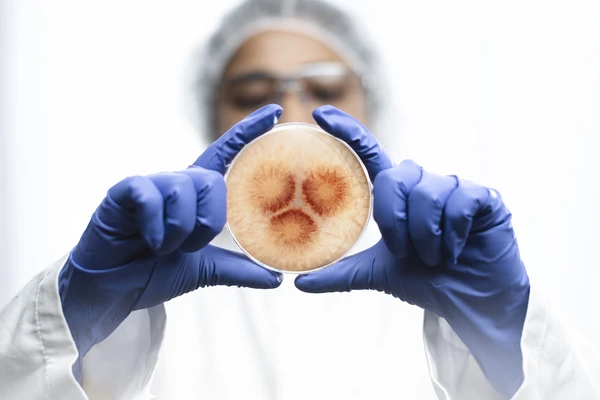
scientist holding petri dish

The world of food and beverages,
made better
We harness and amplify the power of cultures and enzymes in our biosolutions so you can make the world of food and beverages even better with biology.
Why choose our biosolutions?
For thousands of years, culinary traditions across the globe have been shaped by biology in the form of cultures and enzymes. Today, we harness and amplify biology in biosolutions, so you can shape tomorrow’s traditions.
With our biosolutions, you can give people more of what they want and less of what they don’t. You can also cut costs and improve quality, while maintaining the authenticity your consumers love.
Extend your possibilities
Biosolutions extend possibilities to make the world of food and beverages better. Find out how they can help you stay ahead in a changing world.


Give people more of what they want & less of what they don’t
Give people more of the freshness, tastes, textures, appearances and nutrition they want with biosolutions. Reduce your need for the things they don’t, such as texturizers and artificial sweeteners. Cut sugar, salt and unwanted fat levels. And reduce food waste to give people the more sustainable products they want.

Cut costs & improve quality
Two billion more people to feed by 2050, tariff uncertainty, inflation and volatile raw material prices. Now, more than ever, you need to maximize your productivity. Biosolutions can help, while reducing your dependence on volatile chemical supply chains. All while improving the quality of your products.

Leverage our biological heritage & shape the future
For millennia, we’ve used biology to craft our rich tapestry of food and beverage traditions. Now biology - in the form of biosolutions - can help you get ahead of key shifts including front of package labeling and the backlash against UPFs. And they can help you drive your sustainability agenda forward.

Hands-on today & eyes on tomorrow
It's our business to understand your business and help make it better. With deep application knowledge, our technical service team can offer hands-on support in your local language – fast. And with our eyes on tomorrow, we can help you find and fill white space in your markets through insights-driven co-creation.

All the biosolutions you need & all you can imagine
With enzymes, cultures, probiotics, yeasts and proteins, our strong toolbox offers all the biosolutions you need. And with an 11% reinvestment into R&D, a 2,000-strong R&D team and a unique understanding of the synergistic potential of biosolutions, we’re ready to develop all the biosolutions you can imagine.
The scale to deliver & the quality to perform
With 30+ production sites across four continents, we have a unique ability to scale up biosolutions, fast. And we have the quality to perform, with robust, stable biosolutions delivered through multiple distribution centers worldwide. We ship 100,000+ orders annually, with more than 97% shipped on time.
Perspectives on the future of food & beverages
In the Table Talks series, our experienced experts share strategic foresight and insights on key topics, from growing industry pressures to the importance of getting the fundamentals right.
Watch now to expand your horizons and extend your possibilities.

Labels matter
more than ever
92% of consumers care about ingredient lists. But what does that mean for your brand?
Our new global study, surveying over 6,300 people, reveals how consumers interact with labels, what builds their trust, and what makes them choose one product over another.
Learn how you can turn our insights into action and deliver more of what people want and less of what they don’t. Download the free white paper now.

Making the world of food and beverages better
Cheese people love with less waste
Biosolutions can help improve cheese firmness to reduce waste in slicing, dicing and grating. In continental cheese production, for example, they’ve cut losses by up to 40%. And across cheese types, they play a key role in crafting the depth and complexity of flavor that makes people love cheese.

Better baked goods
Biosolutions deliver both consumer-relevant and processing benefits in baking. They make products more appealing and help optimize recipes and production processes. They make dough rise up to 20% more efficiently and increase volume by up to 30% — all while ensuring longer-lasting freshness.

Beer with better aroma and half the malt
Sales of non-alcoholic beer are booming. One brewery hoped to take advantage of this trend through thermal dealcoholization. But the resulting beer lacked aroma. Switching to biosolutions improved aroma and led to malt savings of more than 50%.

Simple-recipe seafood with less risk of Listeria
After the discovery of Listeria in an Australian smokehouse’s products led to two national product recalls, the smokehouse turned to fermentation-enabled bioprotection. The result: reduced risk of Listeria growth with the simple recipes to which the smokehouse is committed.

Unmatched barista foam in dairy-free coffee
An ability to deliver barista-quality foam sets plant-based drinks apart. Our biosolutions support superior foaming qualities and improved foam height. They also prolong stability without curdling. And they unlock higher protein.

Beverages that bring good bacteria back
50% of the microbial diversity in our gut microbiome may be lost1. To help bring it back, one beverage producer functionalized their beverage with our probiotic. Now they can ensure that the all-important one billion colony-forming units of good bacteria benefit consumers throughout 12 months’ shelf life.

Find biosolutions for your industry
Insights to better the world of food and beverages
Whitepapers, reports, webinars and insights studies. These are just a few of the resources on our LinkedIn pages that can help you make the world of food and beverages better.